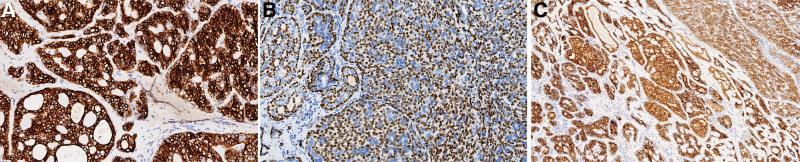
https://cdn.ncbi.nlm.nih.gov/pmc/blobs/966c/9666223/6b861b79892b/medi-101-e31744-g004.jpg

巴氏腺腺样囊性癌易误诊:病例报告及文献复习。
Adenoid cystic carcinoma of the Bartholin's gland is easily misdiagnosed: A case report and literature review.
机构信息
Department of Pathology, Hangzhou Women's Hospital, Hangzhou, Zhejiang, China.
Department of Ultrasound, Hangzhou Women's Hospital, Hangzhou, Zhejiang, China.
出版信息
Medicine (Baltimore). 2022 Nov 11;101(45):e31744. doi: 10.1097/MD.0000000000031744.
RATIONALE
Adenoid cystic carcinoma (ACC) often occurs in the major and minor salivary glands and other sites containing secretory glands, while ACC of the Bartholin's gland (BG-ACC) in the vulva is rare and easily misdiagnosed.
PATIENT CONCERNS
A 58-year-old female was referred to our hospital for further valuation of a mass occurring on the left side of her vulva. In the other hospital, the beginning of the period, local ultrasound showed a vulva mass, which was suspected to be a Bartholin's gland cyst. Mixed neoplasms were considered in some biopsies. When transferred to our hospital, virtuous tumors were considered by ultrasound and magnetic resonance imaging. Pathology initially considered benign hyperplastic active tumor or borderline tumor.
DIAGNOSES
Histological, immunochemical, and molecular tests confirmed a diagnosis of BG-ACC, negative surgical margin, without lymphatic metastasis.
INTERVENTIONS
Extended excision of the mass at left labia majora plus left inguinal lymph node dissection was performed.
OUTCOMES
The patient received surgery therapy, no recurrence was observed during a 18-month follow-up period.
LESSONS
Due to its lack of specific characteristics in clinical, ultrasound and imaging, it is easy to be misdiagnosed, Due to its rarity and nonspecific clinical, radiologic and ultrasonographic manifestations, BG-ACC can be easily misdiagnosed. And its pathomorphological features overlap with other benign and malignant tumors occurring at vulva, BG-ACC can be easily misdiagnosed, and diagnosis by puncture biopsy is extremely difficult. Use of paraffin sections to identify tumor growth characteristics, combined with immunohistochemical findings, is the key to the diagnosis of ACC. In rare sites, MYB gene split are helpful in making a definite diagnosis.
背景
腺样囊性癌(ACC)常发生于大、小唾液腺及其他含分泌腺的部位,而外阴巴氏腺(BG-ACC)的 ACC 则罕见,易误诊。
患者关注
一名 58 岁女性因左侧外阴出现肿块而被转至我院进一步评估。在另一家医院,初诊时,局部超声显示外阴肿块,疑似巴氏腺囊肿。部分活检考虑为混合性肿瘤。转至我院时,超声和磁共振成像考虑为良性肿瘤。最初的病理检查考虑为良性增生性活性肿瘤或交界性肿瘤。
诊断
组织学、免疫化学和分子检测证实为 BG-ACC,切缘阴性,无淋巴转移。
干预
行左侧大阴唇肿块扩大切除术加左侧腹股沟淋巴结清扫术。
结果
患者接受了手术治疗,18 个月的随访期间未观察到复发。
教训
由于其在临床、超声和影像学上缺乏特异性,易误诊。由于其罕见性和非特异性的临床、放射学和超声表现,BG-ACC 容易误诊。其病理形态学特征与外阴其他良性和恶性肿瘤重叠,BG-ACC 容易误诊,穿刺活检诊断极其困难。使用石蜡切片识别肿瘤生长特征,结合免疫组化结果,是 ACC 诊断的关键。在罕见部位,MYB 基因分裂有助于明确诊断。